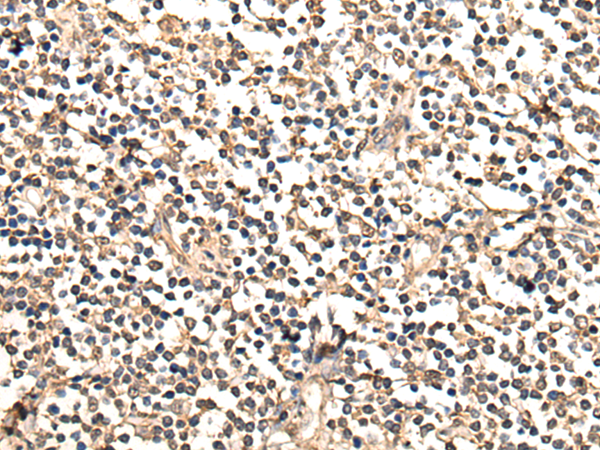
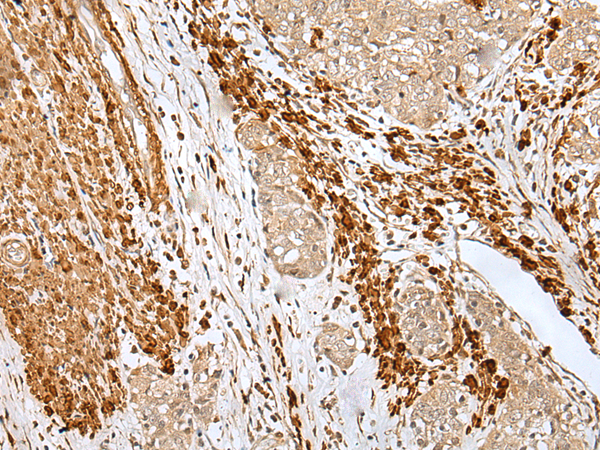
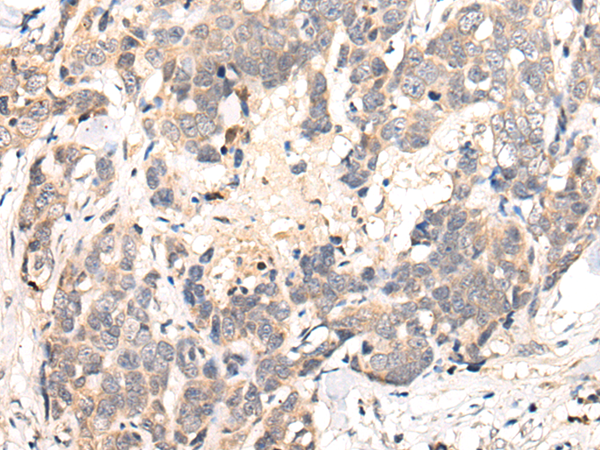

-
分类: 科研抗体货号: P12536别名: CJS; HPE9; PHS2; THP1; THP2应用: IHC反应种属: Human, Mouse
-
分类: 科研抗体货号: P12555别名: CAK; p34; p37; CycH应用: WB,IHC反应种属: Human, Mouse, Rat
-
分类: 科研抗体货号: P12554别名:应用: IHC反应种属: Human, Mouse
-
分类: 科研抗体货号: P12565别名: HD5; NY-CO-9应用: IHC反应种属: Human, Mouse
-
分类: 科研抗体货号: P12580别名: Nbla00170应用: IHC反应种属: Human
-
分类: 科研抗体货号: P12564别名: PF-4; CXCL4; SCYB4应用: IHC反应种属: Human
-
分类: 科研抗体货号: P12579别名: NACHRA9; HSA243342应用: WB,IHC反应种属: Human, Rat
-
分类: 科研抗体货号: P12563别名: Eaf3; MEAF3; MRG15; FWP006; S863-6; HsT17725; MORFRG15应用: WB,IHC反应种属: Human, Mouse, Rat
-
分类: 科研抗体货号: P12578别名: CHNRA6应用: IHC反应种属: Human
-
分类: 科研抗体货号: P12562别名: D6S231E应用: IHC反应种属: Human, Rat

鄂公网安备42018502007531号
鄂公网安备42018502007531号

